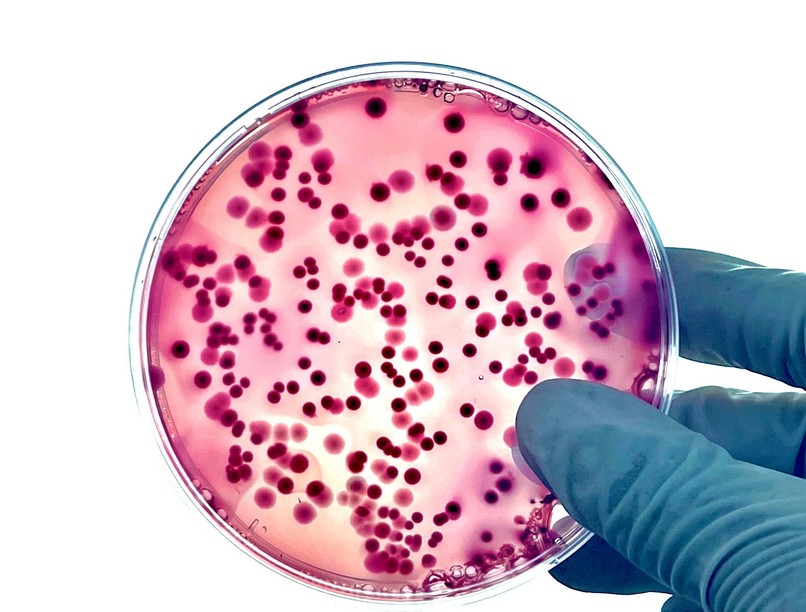
antibiotikum rezisztencia vírus szuperbaktérium

A kórházi gyakorlatban a probléma pont az, hogy nemcsak egy antibiotikummal szemben válnak ellenállóvá, hanem úgynevezett szuperbaktériummá válnak: nemcsak hogy rendkívül fertőzőek, és komoly megbetegedéseket okoznak, hanem eközben egyszerre több, legrosszabb esetben szinte az összes antibiotikummal szemben is ellenállóvá válnak.
A közeljövő egyik legsúlyosabb egészségügyi problémájáról, a baktériumok antibiotikum-rezisztenciájáról, az ez elleni küzdelemről és a lehetséges megoldásokról beszélt Pál Csaba és Papp Balázs evolúcióbiológus az MTA idei Tudományünnep+ sorozatának november 7-i előadásán.
Antibiotikumokkal és vírusokkal a szuperbaktériumok ellen címmel tartott november 7-én közös előadást a Magyar Tudományos Akadémia székházában Pál Csaba és Papp Balázs. A HUN-REN Szegedi Biológiai Kutatóközpont két evolúcióbiológusa áttekintette az antibiotikumoknak ellenálló kórokozótörzsekkel, az úgynevezett szuperbaktériumokkal kapcsolatos kutatások helyzetét, két részből álló előadásuk egyik fő kérdésköre azt volt, vajon az új típusú antibiotikumok képesek-e felvenni a versenyt a világszerte terjedő szuperbaktériumok alkalmazkodóképességével, és mit lehet tenni, ha a hagyományos gyógyszerek már nem hatnak.
Pál Csaba, az MTA levelező tagja, a HUN-REN Szegedi Biológiai Kutatóközpont tudományos tanácsadójaként kutatócsoportjával azt vizsgálja, milyen molekuláris mechanizmusok befolyásolják az antibiotikum-rezisztencia kialakulását, felfedezhetők-e a hátterükben általános törvényszerűségek. Pál Csaba szerint az antibiotikumok az orvostudomány csodái közé sorolhatók, ám van velük egy apró probléma: bármilyen új antibiotikum kerül is piacra, előbb vagy utóbb nehézkessé, végső soron hatástalanná válik vele a kezelés. A kutató tapasztalata szerint az antibiotikumoknak ellenálló, a szaknyelvben rezisztensnek hívott baktériumtörzsek laboratóriumi körülmények között pár hét leforgása alatt ki tudnak alakulni bármilyen új antibiotikum esetében. A legnagyobb fejfájást a kutatóknak az okozza, hogy sokszor olyan genetikai változások történnek bennük, olyan mutációk jönnek létre, amelyek egyszerre tartják meg ellenálló és fertőzőképességüket.
Ráadásul a kórházi gyakorlatban a probléma pont az, hogy nemcsak egy antibiotikummal szemben válnak ellenállóvá, hanem úgynevezett szuperbaktériummá válnak: nemcsak hogy rendkívül fertőzőek, és komoly megbetegedéseket okoznak, hanem eközben egyszerre több, legrosszabb esetben szinte az összes antibiotikummal szemben is ellenállóvá válnak. Hogy mennyire súlyos a helyzet? Az ehhez kapcsolódó halálesetek száma évről évre nő.
Nagyon gyakran azt mondják, hogy ez egy világméretű és növekvő egészségügyi kockázat. Van, aki csendes világjárványról beszél – fogalmazott Pál Csaba, aki szerint a tudósok, a gyógyszerkutató cégek és az orvosok egy fegyverkezési verseny közepén állnak: bármilyen antibiotikumot fejlesztenek is ki, azokkal szemben rendre kialakul az ellenálló képesség. A profitorientált gyógyszergyáraknak sem éri meg már az antibiotikumok fejlesztése: ha az esetenként több 100 millió dolláros befektetéssel kifejlesztett új gyógyszerek piacra dobásuk után elvesztik hatásosságukat, akkor a profit annyira alacsony lesz, hogy a gyógyszeripari cégek előbb-utóbb visszafogják ezt az ágazatot.
A szuperbaktériumok elleni harcban új megoldásokat kereső kutatók szerint megoldás lehet, ha nem új antibiotikumokkal, hanem a meglévő antibiotikumok sajátos kombinációival kísérlik meg legyőzni az új kórokozókat.
„Ha egyszer az a probléma, hogy egy kórokozót egy antibiotikum csak egy ponton támad, akkor próbáljuk meg egyszerre több ponton támadni. Tehát használjunk különböző antibiotikumokat, amelyeknek más-más a hatásmechanizmusuk, máshogy próbálják támadni az adott kórokozót” – mondta Pál Csaba, majd hozzátette, annak az esélye, hogy ezzel szemben kialakul az ellenálló képesség, rendkívül csekély, mert ahhoz, hogy az adott antibiotikum-koktél hatástalan legyen, egyszerre kellene sok ritka genetikai eseménynek, sok ritka mutációnak bekövetkeznie.
Egy másik elképzelés szerint egészen új alapon, a mesterséges intelligenciát segítségül hívva, egyszerre több millió potenciális hatóanyagot vizsgálva kellene gondolkozni az antibiotikum-fejlesztésben, míg egy harmadik megoldás lehet, ha bakteriofág vírusokkal támadjuk a kórokozókat.
Ez utóbbiról már Papp Balázs biológus, az MTA levelező tagja, a HUN-REN Szegedi Biológiai Kutatóközpont csoportvezetője beszélt előadásában.
Mint azt Papp Balázs is kiemelte, az eddigi kutatások eredményei aggasztóak: a vizsgált szerek többsége ellen rövid időn belül kialakul a rezisztencia, vagy eleve jelen van a természetben. Az egyik ígéretes alternatíva a fágterápia. Ennek során olyan, az emberre teljesen ártalmatlan vírusokat vetnek be, amelyek célzottan csak a baktériumokat pusztítják el. Ezek a bakteriofágok olyan vírusok, amelyek a baktériumok természetes ellenségei. Az a dolguk, hogy szaporodjanak a baktériumokban, elpusztítsák őket, de közben az emberi szervezetet egyáltalán nem támadják. Rátapadnak a baktérium sejtfalára, bejuttatják saját genetikai állományukat, avagy a tervrajzot, ami alapján szaporodnak, majd amikor már nagyon sokan vannak, kipukkasztják, és ezzel elpusztítják a sejtet.
A módszer széles körű elterjedésének azonban eddig volt egy komoly akadálya: a fágok túlságosan szűk hatókörűek, rendkívül specifikusak, vagyis egy-egy fajtájuk csak nagyon kevés baktériumváltozat ellen hatásos. Mint az előadásból kiderült, a genomika segíthet ennek a problémának a megoldásában. A modern genetikai elemzésekből kirajzolódó „világtérkép” megmutatja, hogy egy-egy régióban a fertőzések döntő többségét mindössze néhány helyileg domináló baktériumtípus okozza. Ez a felismerés új stratégiát kínál a jövő terápiáihoz: lehetővé teszi célzott, régióspecifikus fágkészítmények fejlesztését.
A hatalmas adathalmazokkal dolgozó térkép még egy dologban segíti a kutatókat: lényegében fel tudják állítani a baktériumok családfáját, akár több százezer baktériumra is. És ha odarakják a családfa mellé a pontos földrajzi információt, hogy melyik baktériumot hol, melyik ország melyik városának melyik kórházában találták meg, akkor lényegében a terjedést is rekonstruálni lehet, ami a járványok elleni küzdelemben kritikus fontosságú lépés.
Az előadásról készült felvétel alább megtekinthető:
Összegzés
- Az antibiotikum-rezisztencia a modern orvostudomány egyik legsúlyosabb globális problémája.
- A szuperbaktériumok ellenállóvá válnak többféle antibiotikummal szemben is, veszélyeztetve a gyógyítást.
- Pál Csaba és Papp Balázs kutatói előadása bemutatta az evolúcióbiológiai kutatásokat ezen a területen.
- Új megoldások között szerepel az antibiotikum-kombinációk és a fágterápia alkalmazása.
- A bakteriális családfák és a terjedési minták elemzése segíti a fertőzések elleni harcot.

Elkeserítő eredmények: a jövő antibiotikumai hatástalanok lesznek a baktériumokkal szemben
Kövesse az Egészségkalauz cikkeit a Google Hírek-ben, a Facebook-on, az Instagramon vagy a X-en,Tiktok-on is!